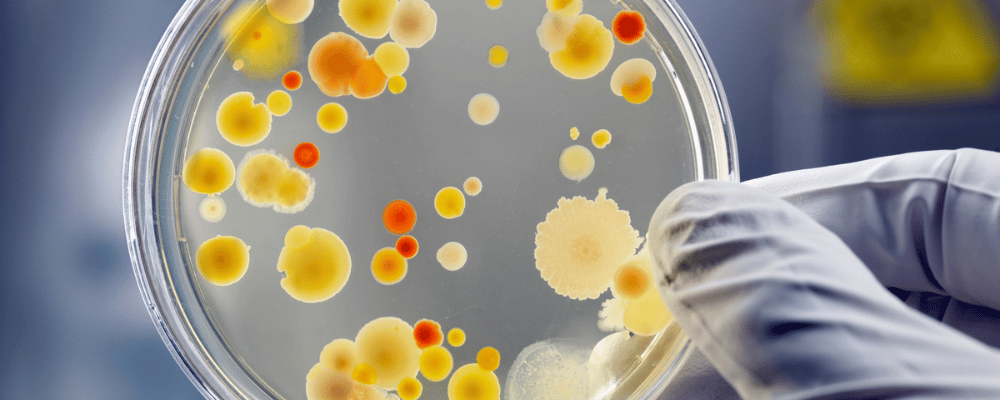
Petrischale mit Bakterien

Für den Umgang mit Biologischen Arbeitsstoffen an Schulen und weiteren Aspekten zur Sicherheit im Biologieunterricht, wie zum Beispiel die Organisation und Führung einer Sammlung, finden Sie wichtige Informationen in der Broschüre Sicherheit im Biologieunterricht – Handlungshilfe für fachkundige Lehrkräfte der Unfallkasse Baden-Württemberg (UKBW), des Kultusministeriums Baden-Württemberg und des Zentrums für Schulqualität und Lehrerbildung Baden-Württemberg (ZSL).
Weitere Handlungshilfen sind auf der Seite Handlungshilfen für den Biologieunterricht unter „Themenspezifische Hinweise“ hinterlegt.
Muster-Gefährdungsbeurteilungen für den Umgang mit Biologischen Arbeitsstoffen finden Sie unter dem Menüpunkt Gefährdungsbeurteilungen für den Biologieunterricht.